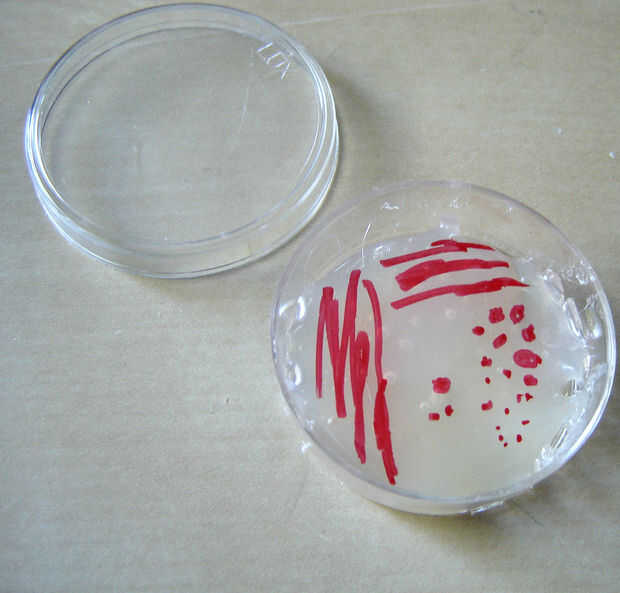

mi novia no era cool y geeky, principalmente porque nuestras familias están llenas de personas que no obtienen lo... :) Pero creo que resultó bastante agradable. Nuestra boda se llevó a cabo en un viñedo en Illinois Central, con un tema del otoño. Me
Añadir un pop de color--o más--para tu refrigerador con este proyecto simple imán!Paso 1: Obtener su materialPara hacer estos imanes de colores, necesita...piezas de azulejo de vidrio (estoy usando color de rosa, amarillo, verde y violeta)cuadrados d
Una decoración sencilla pieza realizada con elementos desde el almacén del dólar!** Ver el TUTORIAL completo arriba **Paso 1: Dino imanes: materialesDinosaurios de plásticoCuchillo afiladoPintura en aerosol oroTiras de imánPistola de pegamento calien
Queríamos un único guardar el regalo de la fecha, algo que nuestros clientes realmente pueden mantener más allá de nuestra boda! Después de buscar algo más que los calendarios imán impreso generalmente, nos decidimos por hacer nuestra propia!Paso 1:
¿No pueden permitirse costoso Lego, necesitan una nueva idea para los estudiantes y los niños o encanta Minecraft? Bueno, no busque más! He creado originalmente para mi English board cuando era profesor asistente de idioma en Japón. Se atan las fotos
No soy mucho de un creyente en la energía libre y cada vez que escucho el término de energía libre la pregunta qué es tan libre sobre ella. Incluso si usted hace un dispositivo de movimiento perpetuo, éter compré o lo hizo. Es tu tiempo no vale nada,
Hola fans de la ciencia y química. En este instructable le demostraré cómo hice un conjunto completo de 120 de fichas magnéticas.Uso: decoración. Refrigerador, gabinete de archivo, cualquier superficie magnética!Paso 1: imprimir Lo primero que hice f
hacer bastante dulces imanes de tus dulces favoritosPaso 1: ingredientes 1 imanestipo de ferrita o neodimio. lo que hacen2. dulcesuno envuelto individualmente3. el papel de tejido4. celofán cintaPaso 2: Eat'em Abierto papel de envolver y comer el car
Mi niño le encanta jugar con los imanes en la nevera, pero la mayoría de ellos es demasiado difíciles para sus pequeños dedos o demasiado delicados para su juego groseros.Este proyecto es un poco de una desviación de mi Instructables de tecnología-pe
Esto podría ser el proyecto más simple jamás he publicado en instructables. Y sin embargo muy práctico. En vez de comprar caros imanes usted puede conseguirlos gratis! A seguir leyendo.Paso 1: Se necesita:un auricular viejoPaso 2: Destripar en Vamos
Mayoría de nosotros tenemos un montón de basura que CD de ahí en nuestro hogar. Se puede utilizar para crear una artesanía maravillosa y colorida para fines distintos.Aquí podemos ver las artesanías recicladas de CD como posavasos, tapices e imanes d
¡Hola!NUEVO VIDEO TODOS LOS LUNES Y JUEVES!Suscríbete aquí: http://www.youtube.com/craftofgiving1¿Oh qué bueno es juego de tronos? Soy obessed con ese show! En este video muestro como se pueden hacer su propio polímero arcilla imanes familia Stark. H
Super sencillo pero delicado encanto imanes de nevera de arcilla y cobre. Una vez seco este material tiene una textura realmente hermosa que contrasta con el cobre de una manera realmente hermosa...Paso 1:Necesitarás algunos arcilla de aire seco. Usé
Luces de bicicleta pueden ser frustrante y lenta para colocar y quitar, sobre todo con mal tiempo con guantes! Mediante la adición de imanes y sus luces, su bicicleta, podrás ajustar las luces y apagar con los guantes y en cuestión de un movimiento m